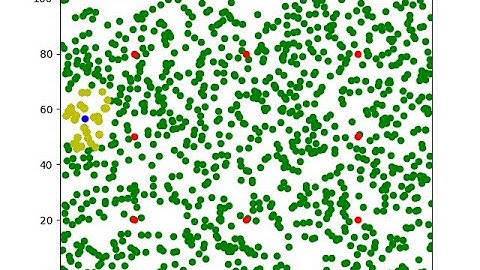
20250311 Monte Carlo Localization demo, How to run Python Matplotlib in C++ with VS Code (Win11)

⬇ DOWNLOAD NOW
Jika muncul iklan pop-up, tutup lalu klik tombol kembali
Download lagu C++ : C++ interface for matplotlib secara gratis hanya untuk keperluan promosi. Dukung artis favorit kamu dengan membeli musik original di iTunes atau platform resmi lainnya.
 Install, Configure & Run Matplotlib for C++ in Visual Studio 2019
Install, Configure & Run Matplotlib for C++ in Visual Studio 2019 How to Install matplotlib-cpp for Windows Visual Studio 2022
How to Install matplotlib-cpp for Windows Visual Studio 2022 Plotting From C++ Using Python Part 1: Introduction
Plotting From C++ Using Python Part 1: Introduction C++ in Python the Easy Way! #pybind11
C++ in Python the Easy Way! #pybind11 Install and Run Matplotlib for C++ in VS Code | Windows
Install and Run Matplotlib for C++ in VS Code | Windows Just Write an HTTP Server?? #programming #coding #lowcode
Just Write an HTTP Server?? #programming #coding #lowcode 20250311 Monte Carlo Localization demo, How to run Python Matplotlib in C++ with VS Code (Win11)
20250311 Monte Carlo Localization demo, How to run Python Matplotlib in C++ with VS Code (Win11) Plotting with Pandas
Plotting with Pandas